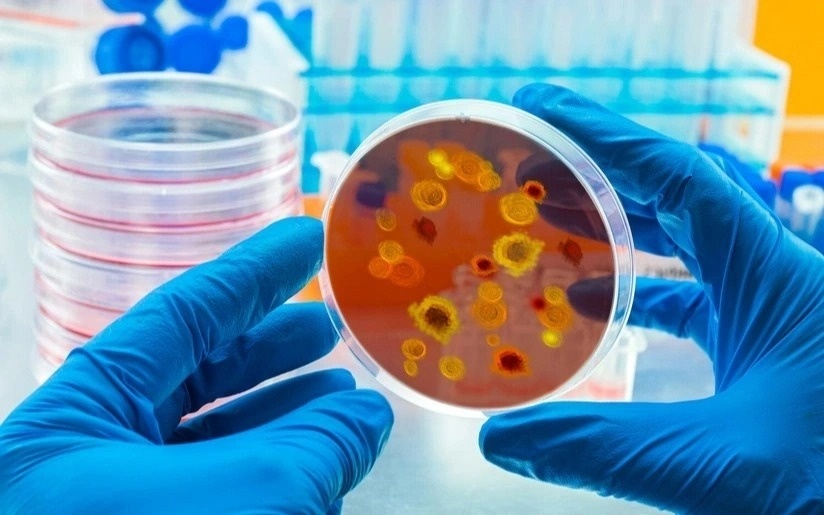
В ЗКО число кишечных инфекций выросло на 19,6%

В Казахстане в 2021–2025 годах саксаул высадили на 1 млн 90 тыс. гектаров высохшего дна Аральского моря. Из этого объема 432,5 тыс. гектаров приходятся на Кызылординскую область. Работа ведется по поручению президента Касым-Жомарта Токаева для улучшения экологической ситуации в регионе.
Площадь высохшего дна Аральского моря составляет 6 млн гектаров, из которых 2,8 млн гектаров находятся на территории Казахстана. Ежегодно с этих участков ветром поднимаются миллионы тонн песка и пыли, которые оседают на орошаемых полях, пастбищах и в садах, снижая их продуктивность. Это сокращает сельскохозяйственный земельный оборот и негативно влияет на экологию и здоровье населения.
В управлении природных ресурсов и регулирования природопользования Кызылординской области отмечают, что практика последних 25 лет показывает: наиболее эффективным способом защиты от переноса соли и пыли остается высадка галофитных растений, в том числе саксаула, сарсазана и соляноколосника.
По данным ведомства, в прошлом году в Кызылординской области была запланирована и полностью выполнена посадка на 100 тыс. гектаров. Из 328 тыс. гектаров, намеченных Комитетом лесного хозяйства и животного мира, работы выполнены на 318 тыс. гектаров. Оставшиеся 10 тыс. гектаров планируется завершить в апреле этого года.
Также в области провели лесовосстановление на 26,5 тыс. гектаров с низкой приживаемостью. На эти цели в 2022 году из республиканского бюджета направили 403,1 млн тенге. В последующие годы средства в таком же объеме выделялись из областного бюджета.
Контроль за лесопосадками и работой саксаулового питомника осуществляет комиссия территориальной инспекции лесного хозяйства и животного мира. В нее входят специалисты профильного комитета, лесохозяйственных учреждений Аральского и Казалинского районов, а также научные сотрудники Института ботаники и фитоинтродукции. Государственный контроль в сфере восстановления и выращивания лесов возложен на областную территориальную инспекцию.
Согласно правилам, утвержденным Министерством сельского хозяйства, приживаемость и сохранность лесных культур в Кызылординской области установлена на уровне 30%. Средняя всхожесть посевов составляет от 26% до 35%.
Научные институты провели исследования почвы и проектные работы на площади 1 млн 71 тыс. гектаров. По итогам этой работы установлено, что посадки саксаула закрепили пески, снизили эрозию почвы, уменьшили распространение соляной пыли и способствовали улучшению экологической ситуации. Это создает условия для восстановления природной экосистемы.
По данным управления, на территории Кызылординской области находятся 7,3 млн гектаров государственного лесного фонда, из которых 3,9 млн гектаров составляют лесные массивы. На 83% площадей лесного фонда произрастает саксаул.